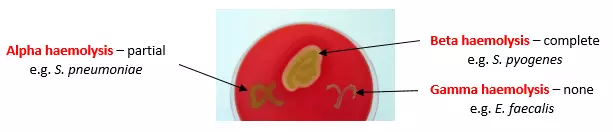
Streptococcal Haemolytic Patterns SimpleMed Streptococcal Haemolytic Patterns SimpleMed

Next Lesson - Hepatitis
Next Article - Hepatitis
Abstract
- Streptococci are a group of Gram-positive cocci usually grouped in chains
- They are classified based upon their haemolytic properties (alpha haemolysis, beta haemolysis and non-haemolytic gamma), serological specificity and biochemical characteristics.
- Streptococcus pyogenes contains multiple virulence factors which facilitate bacterial replication in the host.
- S. pyogenes can cause a variety of serious conditions due to its virulence factors machinery that allows it to withstand adverse conditions from the host immune system.
- Conditions caused by S.pyogenes include: streptococcal pharyngitis, impetigo, cellulitis, necrotising fasciitis and toxic shock syndrome among others.
Core
Classification of Streptococci
Streptococci are a genus of Gram-positive cocci that usually assemble linearly forming chains.
Streptococci are classified based on their haemolytic properties:
- (Alpha) α haemolysis - these species have the ability to oxidise iron in haemoglobin molecules (partial haemolysis), hence the characteristic greenish colour that emanates around them when cultured on a blood agar plate. Some examples belonging to this group include: S. pneumoniae and the group of ‘viridans’ (literally green) streptococci.
- (Beta) β haemolysis - these species cause complete breakdown of red blood cells, hence resulting in the characteristic transparent ‘halo’ (full haemolysis) surrounding the colonies when cultured on a blood agar plate. An important example being S. pyogenes.
- (Gamma) γ haemolytic species - these species cause no haemolysis and simply appear as normal colonies on a blood agar plate, not creating any discolouration or ‘halo’ around them. One example is Streptococcus bovis.
Figure: Different haemolytic patterns
Creative commons source by Y tambe, edited by Dr. Elena Perez [CC BY-SA 3.0 (http://creativecommons.org/licenses/by-sa/3.0/)]
There are a few other ways to describe streptococci. One of them is known as Lancefield grouping and is based on cell wall antigens: it describes the specific carbohydrates found on the bacterial cell wall (group A to V)(group B strep which causes neonatal sepsis is based on this grouping). The other way of classifying Streptococci, known as Sherman’s grouping, is based on their physiological properties and describes whether the streptococcus species is pyogenic, viridans, enterococcal or lactic. So, for example, S. pyogenes is described as beta-haemolytic, pyogenic (both Sherman) and group A (Lancefield).
Many streptococci are part of our normal flora. However, there are a number of virulence factors (molecules and mechanisms that increase a bacterium’s effectiveness and ability to multiply) that render pathogenic species challenging for the body to eliminate on its own.
Let’s look at Streptococcus pyogenes as an example: some of its virulence factors proper to group A streptococci include:
- M protein which promotes resistance by inhibiting activation of the alternative complement pathway; it also promotes initial attachment
- A large hyaluronic acid capsule that prevents recognition and phagocytosis by macrophages and neutrophils (as it mimics human connective tissue hyaluronate);
- Pyrogenic exotoxins that act as superantigens, triggering widespread T cell activation and cytokine release
- Streptokinase which dissolves clots by converting plasminogen into plasmin;
- Streptolysins O and S that cause lysis of the host’s erythrocytes, neutrophils and platelets;
- DNAses A, B, C and D that cause degradation of DNA.
N.B. Not all S. pyogenes are equipped with all these virulence factors as there is variation between strains.
Diseases caused by S. pyogenes infections
One of the clinical manifestations of a S. pyogenes infection is streptococcal pharyngitis commonly referred to as Strep throat. It mainly affects children aged 5 to 15 and is transmitted via droplet spread. It arises as a sore throat initially, later accompanied by malaise, fever, headache and eventually swelling of the tonsils which may later take on a characteristic pustulous appearance. The management of streptococcal pharyngitis is guided by clinical assessment and, where appropriate, microbiological testing. In patients with a high likelihood of group A streptococcal infection, antibiotics are recommended to reduce the risk of complications such as acute rheumatic fever, to shorten symptom duration slightly, and to limit transmission. Supportive treatment is also important for symptom control. Furthermore, in times of increasing antibiotic resistance (see our article on antibiotics) antibiotics should only be prescribed when absolutely necessary. However, if the strain also contains pyrogenic exotoxins, the streptococcal pharyngitis can develop into scarlet fever: an additional characteristic rash and fever caused by the erythrogenic action of the toxins. This complication does warrant rapid treatment with antibiotics as does all other complications.

Figure: Typical rash seen in scarlet fever
Public Domain Source Internet [Archive Book Images [No restrictions]]
- Suppurative complications- e.g. peritonsillar abscesses, retropharyngeal abscesses which can spread to the mediastinum causing a severe deep tissue infection with high mortality.
- Acute rheumatic fever- can be caused by any Group A strep infection thought to be caused by binding of M protein to the host’s collagen, possibly also linked to some autoimmune predisposition. It can manifest up to 3 weeks after initial pharyngitis and can affect different parts of the body including: the heart, brain, joints and skin.
- Acute post-streptococcal glomerulonephritis- an acute inflammation of the renal glomerulus caused by deposition of antigen-antibody complexes in the glomeruli.
Some important skin infections caused by S. pyogenes:
- Impetigo: usually affects children between the ages of 2 and 5 and is characterised by a honey crusty lesion. The pathogenesis starts with skin colonisation later developing into intradermal inoculation and is often associated with glomerulonephritis. Usually self-resolving.
- Erysipelas: a superficial skin infection most commonly found on the face and lower limbs. Usually preceded by a sore throat leading to a rapidly developing hot, red and swollen lesion.
- Cellulitis: a deeper infection of skin and subcutaneous tissue infection. Requires some damage to the skin integrity to manifest. Caused by Streptococci and Staphylococcus species including S. aureus.
- Necrotising fasciitis: an infection of the deep tissues and fascia that leads to rapid necrosis. Symptoms usually include severe pain out of proportion to visible signs, often before obvious skin changes, followed by systemic features such as fever. This is a medical emergency with high mortality and requires urgent surgical debridement and prompt IV antibiotics, typically broad spectrum regimens with agents that also suppress toxin production. Further surgery, including amputation, may be required. Diagnosis is ultimately surgical, with findings of extensive tissue destruction.

Figure: Impetigo
Creative commons source by Pp96 [CC BY-SA 4.0 (https://creativecommons.org/licenses/by-sa/4.0)]

Figure: Erysipelas
Creative commons source by Klaus D. Peter, Gummersbach, Germany [CC BY 3.0 de (https://creativecommons.org/licenses/by/3.0/de/deed.en)]

Figure: Cellulitis
Public Domain Image Source https://www.flickr.com/photos/104346167@N06/44699140442

Figure: Necrotising Fasciitis. Note the characteristic blood blisters and widespread damage
Creative commons source by Piotr Smuszkiewicz, Iwona Trojanowska and Hanna Tomczak [CC BY 3.0 de (https://creativecommons.org/licenses/by/3.0/de/deed.en)]
Finally, toxic shock syndrome (TSS) is a very serious reaction to exotoxin-mediated bacterial infection (S. pyogenes, referred to as streptococcal TSS, and Staphylococcus aureus including MRSA). It is typically associated with invasive infection and can quickly progress to bacteraemia, vascular collapse and ultimately organ failure if not recognised early. Patients can deteriorate rapidly over hours. The severity of infection is caused by exotoxins released by the bacteria acting as superantigens, triggering widespread T cell activation and a non-specific systemic inflammatory response leading to vascular collapse.
Edited by: Dr. Ben Appleby and Dr. Marcus Judge
- 8374

